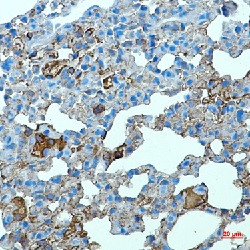
Tlr2 Antibody in Immunohistochemistry (Paraffin) (IHC (P))

Search
Abnova
Tlr2 Recombinant Rabbit Monoclonal Antibody
{{$productOrderCtrl.translations['antibody.pdp.commerceCard.promotion.promotions']}}
{{$productOrderCtrl.translations['antibody.pdp.commerceCard.promotion.viewpromo']}}
{{$productOrderCtrl.translations['antibody.pdp.commerceCard.promotion.promocode']}}: {{promo.promoCode}} {{promo.promoTitle}} {{promo.promoDescription}}. {{$productOrderCtrl.translations['antibody.pdp.commerceCard.promotion.learnmore']}}
产品信息
RAB01645
种属反应
宿主/亚型
Expression System
分类
类型
抗原
偶联物
形式
纯化类型
保存液
内含物
保存条件
运输条件
靶标信息
TLR2 is a member of the Toll-like receptor (TLR) family which play a fundamental role in pathogen recognition and activation of innate immunity. TLR proteins act through adaptor molecules such as MyD88 and TIRAP to activate various kinases and transcription factors such as Protein Kinase C (PKC) alpha/beta and NF-kappa-B. TLR2 can form heterodimers with either TLR1 or TLR6, and as a heterodimer, can recognize a variety of bacterial and mycoplasma lipoproteins respectively. TLRs are highly conserved from Drosophila to humans and share structural and functional similarities. The various TLRs exhibit different patterns of expression. TLR2 is expressed most abundantly in peripheral blood leukocytes, and mediates host response to Gram-positive bacteria and yeast via stimulation of NF-kappaB. TLR2 aids in the recognition of pathogen-associated molecular patterns (PAMPs) that are expressed on infectious agents, and mediate the production of cytokines necessary for the development of effective immunity. Ten human homologs of TLRs (TLR1-10) have been described. TLR2 is expressed in human cells such as tonsils, microglia, lymph nodes, and appendices, activated B-cells in germinal centers. CD14+ monocytes express the highest level of TLR2 followed by CD15+ granulocytes, CD19+ B-cells, and CD3+ T-cells. The expression of TLR2 on different cell types are regulated by different immune response modifiers. For example, LPS, GM-CSF, IL-1, and IL-10 up regulates TLR2 whereas IL-4, IFN-gamma, and TNF down regulate TLR2 expression in monocytes.
仅用于科研。不用于诊断过程。未经明确授权不得转售。
篇参考文献 (0)
生物信息学
蛋白别名: CD282; TLR-2; Toll-like receptor 2
基因别名: Ly105; Tlr2
UniProt ID: (Mouse) Q9QUN7
Entrez Gene ID: (Mouse) 24088